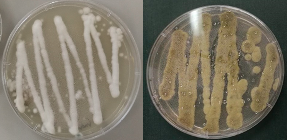

I came to New Zealand in February 2019 to pursue PhD in Ecology at Massey University, for a PhD research focusing on soil Entomopathogenic Fungi (EPF). My study is being funded by the New Zealand Scholarship. Entomology as a science and discipline has always been my first love. I majored in Entomology during my bachelor’s degree and finished MS degree in Entomology minor in Molecular Biology, both at the University of the Philippines Los Baños in 2008 and 2015, respectively. My PhD research concentrate on insect pathology, specifically on entomopathogenic fungi (EPF).
Professionally, I am working as a university researcher at the National Crop Protection Center, College of Agriculture and Food Science, University of the Philippines Los Baños. Currently on study leave, my academic research interests include molecular entomology, insect pathology and crop protection entomology. |
 |
PhD research
My PhD project deals with entomopathogenic fungi in New Zealand soils and its use in biological control of insect pests. Entomopathogenic fungi (EPF) are naturally occurring microorganisms that colonise and grow within living insects that have potential for the control of insect pests. EPF as biocontrol agents have several advantages when compared with conventional insecticides, including reduction of residues in the environment, low risk on non-target organisms and sustainability.
Entomopathogenic fungi are found naturally in soils, but despite their potential for biological control, their occurrence and natural diversity in New Zealand soils are little known. My PhD study investigates the diversity of New Zealand EPF focusing on the North Island and utilizes a comparative approach across exotic pasture and native forest transitions. Several approaches including insect baiting, direct plating, and next generation sequencing (NGS) of soil DNA are employed to assess existing diversity and identify potential strains for control use.
Metagenomics of the soil microbiome is also applied to explore microbial and microarthropod communities in forest and pasture soils in concert with soil fauna analysis. Field collected EPF was used to conduct bioassays in the laboratory against several insect pests including grass grubs, giant willow aphid, among others.
|

Mealworm larvae infected with EPF
Culture of Beauveria bassiana (left) and Metarhizium novazealandicum (right). Culture of Beauveria bassiana (left) and Metarhizium novazealandicum (right).
|

EPF spores viewed using scanning electron microscope. EPF spores at 5,000X (left). EPF spores with hyphal growth (in red arrow) viewed at 12,000X (right).
|

<EPF growth on the insect cuticle (left) and spiracle (right)
|
Current Affiliation
PhD Student, Zoology and Ecology Group, School of Natural Sciences, College of Sciences, Massey University
University Researcher (on study leave), National Crop Protection Center, College of Agriculture and Food Science, University of the Philippines Los Baños, 4031, Philippines
Academic Publications
Guerrero, M.S., Javier P.A, Laude, R.P., and Caoili, B.L. 2019. Genetic Diversity of coconut scale insect, Aspidiotus spp., from outbreak and non-outbreak areas in the Philippines using Internal Transcribed Spacer 2 (ITS2). Philipp Agric Scientist Vol. 102 (Special Issue No. 1): 81-90 2019.
Solleza, Michelle O. and Pio A. Javier. 2009. Ovipositional Preference of Trathala flavoorbitalis Cameron (Hymenoptera: Ichneumonidae), a larval parasitoid of Eggplant Fruit and Shoot Borer, Leucinodes orbonalis Guenee. The Philippine Entomologist. 23(2): 131-148.
Latina RA, Lantican DV, Guerrero MS, Rubico EC, Laquinta JF and Caoili BL. 2022. Species-specific PCR-based marker for rapid detection of Aspidiotus rigidus Reyne (Hemiptera: Diaspididae). Journal of Asia-Pacific Entomology. https://doi.org/10.1016/j.aspen.2021.101848
Qualifications
2015. Master of Science in Entomology (Minor in Insect Molecular Biology and Insect Pathology), University of the Philippines, Los Baños, College, Laguna
2008. Bachelor of Science in Agriculture (Major in Entomology), University of the Philippines Los Baños, College, Laguna
|